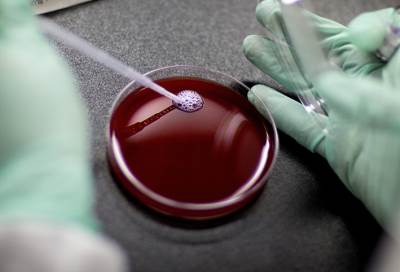
كيف تنمو الأورام داخل الجسم؟

هل يتغير جسم الإنسان بالكامل كل سبع سنوات؟
خاص الجمال
هناك معلومة كانت قد انتشرت في السنين الأخيرة، وهي أن جميع خلايا جسم الإنسان تكون قد تغيرت في فترة سبع سنوات، وقد أثارت هذه النقطة اهتمام الكثيرين، وبرز تساؤل جديد من وجهة نظر منطقية فلسفية.. إذا كان تلك المعلومة صحيحة، فهل أنت نفس الشخص الذي كنته قبل سبع سنوات من الآن؟ للإجابة عن هذا السؤال، يجب علينا أولا أن نعرف طبيعة الخلايا في الجسد البشري، والعمر الافتراضي لكل منها، وذلك فقاً للتقرير الذي نشره موقع "Science ABC".
تتغير الخلايا في جسم الإنسان والحيوانات من خلال عملية تعرف باسم "Mitosis"، ومعناها الانقسام المتساوي أو الانقسام الميتوزي، وهي عملية انقسام الخلية الواحدة إلى خليتين متطابقتين من خلال نسخ الصبغيات، أو الكروموسومات "Chromosomes"، الموجودة داخل نواة الخلية التي تقوم بالانقسام.
العالم السويدي "جوناس فرايزن"، الباحث بمعهد "كارولينكا" بالعاصمة السويدية "استوكهولم"، استخدم طريقة تعتمد على ملاحظة ذرات الكاربون-14 الموجودة في الحمض النووي للبشر، والتي نتجت عن التجارب النووية التي كانت تجريها الولايات المتحدة الأمريكية منذ عشرات السنين، ووجدت طريقها بالفعل إلى الهواء والمزروعات وأجسام الحيوانات والبشر، خاصة هؤلاء الذين ولدوا لآباء عاشوا في الولايات المتحدة الأمريكية.
نشر "جوناس" دراسته في مجلة "Cell"، المتخصصة في بحوث الخلايا، سنة 2005، والتي شملت اختبارات وفحوصات على مجموعة من الأشخاص، كانت أعمارهم جميعاً في آخر الثلاثينيات، وقد وجدوا أن أعمار الخلايا الموجودة في أجزاء الجسم المختلفة تختلف بشكل كبير، فهو يتراوح بين ثلاثة أيام وحوالي 16 عاماً.

خلايا السائل المنوي كانت من أقصر الخلايا عمراً، فعمرها يبلغ 3 أيام، وتأتي بعدها خلايا القولون، بعمر يبلغ 4 أيام، وبلغ عمر النسيج الطلائي الموجود بسطح القناة الهضمية والمعدة حوالي 5 ايام.
وتتغير خلايا الجلد بعد فترة تتراوح من 2 إلى 3 أسابيع، بينما تتغير خلايا كرات الدم الحمراء كل أربعة أشهر تقريبا، تكون قد قطعت فيها داخل الجسم مسافة تتجاوز 300 ميل، ويبلغ عمر كرات الدم البيضاء عاماً كاملاً.
يتجدد الكبد بشكل كامل كل فترة تتراوح بين 300 و500 يوم، ويستغرق الهيكل العظمي للإنسان حوالي 10 أعوام ليكون قد تجدد بشكل كامل، بينما يبلغ عمر النسيج العضلي للإنسان حوالي 15.1 سنة.
وعلى النقيض من النسيج الطلائي للقناة الهضمية، فإن عمر الخلايا المكونة للأنسجة الرئيسية في منطقة البطن يعتبر من أكبر الأعمار بين أجزاء جسم الإنسان المختلفة، حيث يبلغ 15.9 سنة.
إذا كانت كل خلايا جسم الإنسان تتكاثر وتتغير، فإن الأمر يختلف بشكل تام بالنسبة للمخ، فقد اكتشف "جوناس" وفريقه البحثي أن الخلايا العصبية المكونة الموجودة بالمخ لا تتغير، حيث وجد الباحثون أن عمر الخلايا الموجودة بغالبية أجزاء المخ يكون مساوياً لعمر الإنسان نفسه، وهو ما يدل على أن الخلايا العصبية، أو "Neurons"، تتكون في المخ قبل ولادة الإنسان، ولا تموت إلا بموت الإنسان نفسه، أو بسبب أمراض عصبية، وذلك باستثناء الخلايا المكونة لجزء يعرف بـ"المخيخ"، والذي وجد الباحثون أن عمر خلاياه كان أصغر قليلاً من عمر الشخص الذي يتم فحصه.

يتضح مما سبق أن مقولة تغير جسم الإنسان بالكامل خلال سبع سنوات هي مقولة خاطئة، وإن كانت تحمل جزءاً من الحقيقة، وهو أن الغالبية العظمى من خلايا جسم الإنسان تتغير بالفعل، عدة مرات، خلال حياته، ولكن أعمار تلك الخلايا يتراوح بشكل كبير، كما أن الخلايا العصبية المكونة للمخ، والتي تحمل في طياتها الأفكار والذكريات الخاصة بالإنسان، لا تتغير تقريبا منذ لحظة الولادة وحتى الممات.